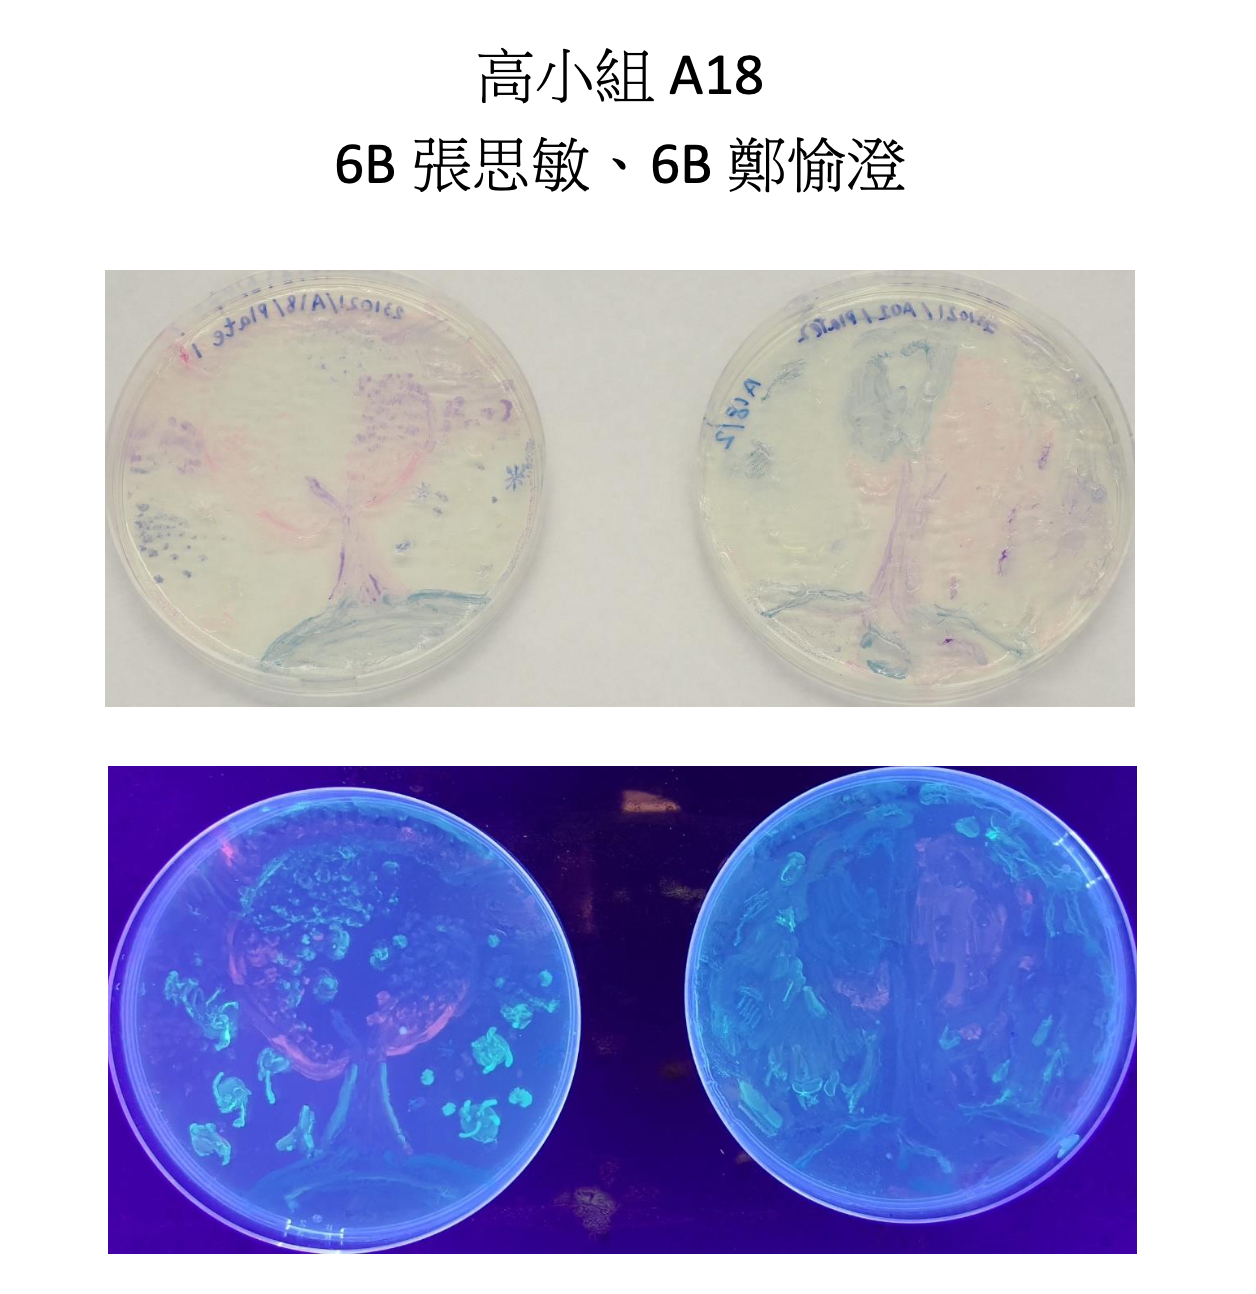
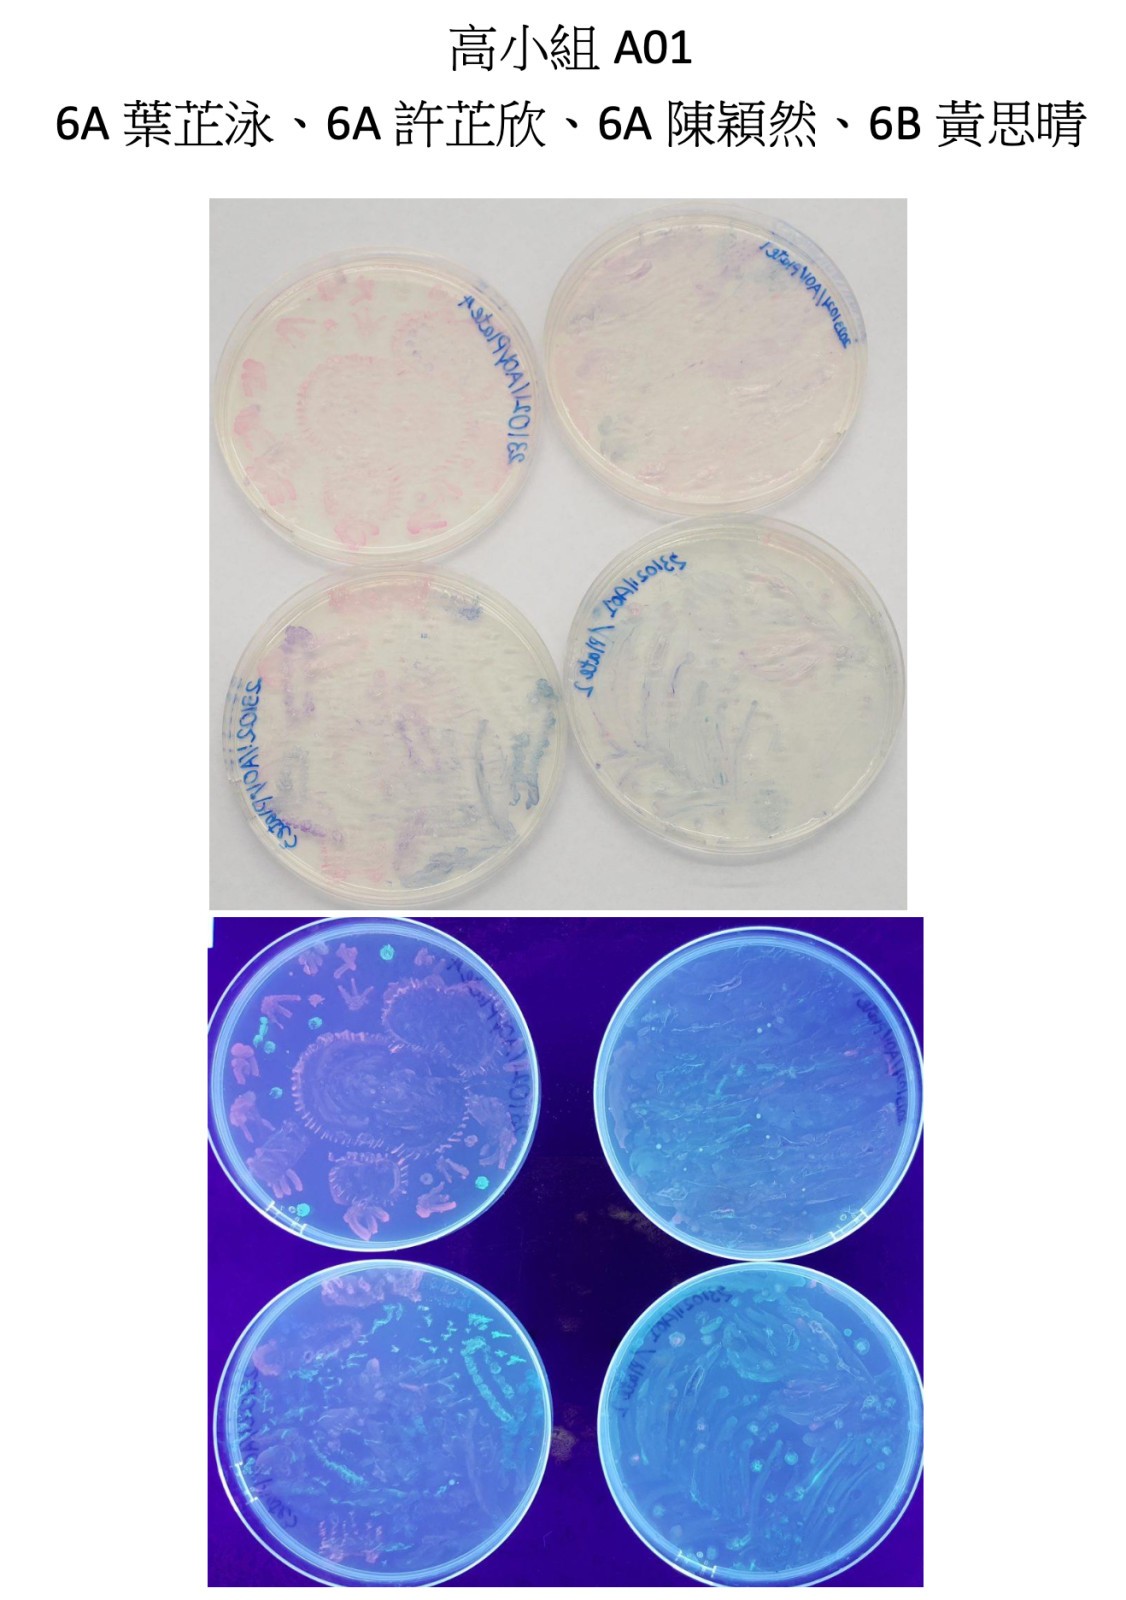

國際瓊脂藝術大賽2023
2023-11-03
6A葉芷泳、6A許芷欣、6A陳穎然、6B黃思晴、6B張思敏和6B鄭愉澄代表本校參加『國際瓊脂藝術大賽2023』香港區賽,以『微生物在太空』為主題創作瓊脂藝術畫作。
現正進行競遂『最受歡迎大獎』,每人在每個組別(高小組、初中組及高中組) 分別只能投一票,如於同一組別重覆投票則視為廢票。
網上投票截止日期為2023年11月19日下午5時正。
誠邀各位家長、學生和老師參與網上投票,一同支持學生的作品。
高小組A01
6A葉芷泳、6A許芷欣、6A陳穎然、6B黃思晴
高小組A18
6B張思敏、6B鄭愉澄
作品展覧及投票專頁:https://ss.hoyu.edu.hk/blog/2023/10/31/asm_agar/
高小組投票網站:https://docs.google.com/forms/d/e/1FAIpQLSeyRsDRd4yETIfwyNuyiBmTwAkK_EyMbDbh1sK3CDn4yCG__Q/viewform